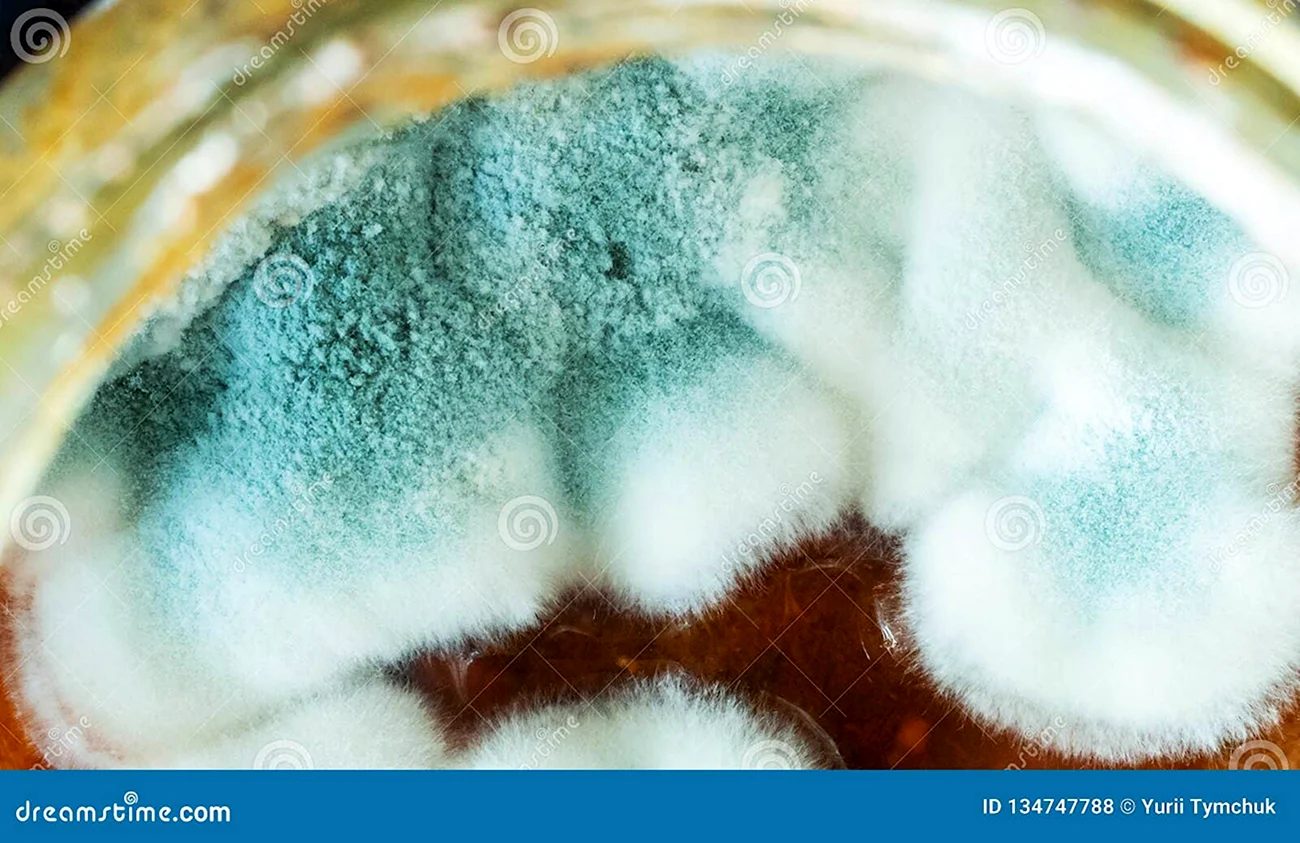
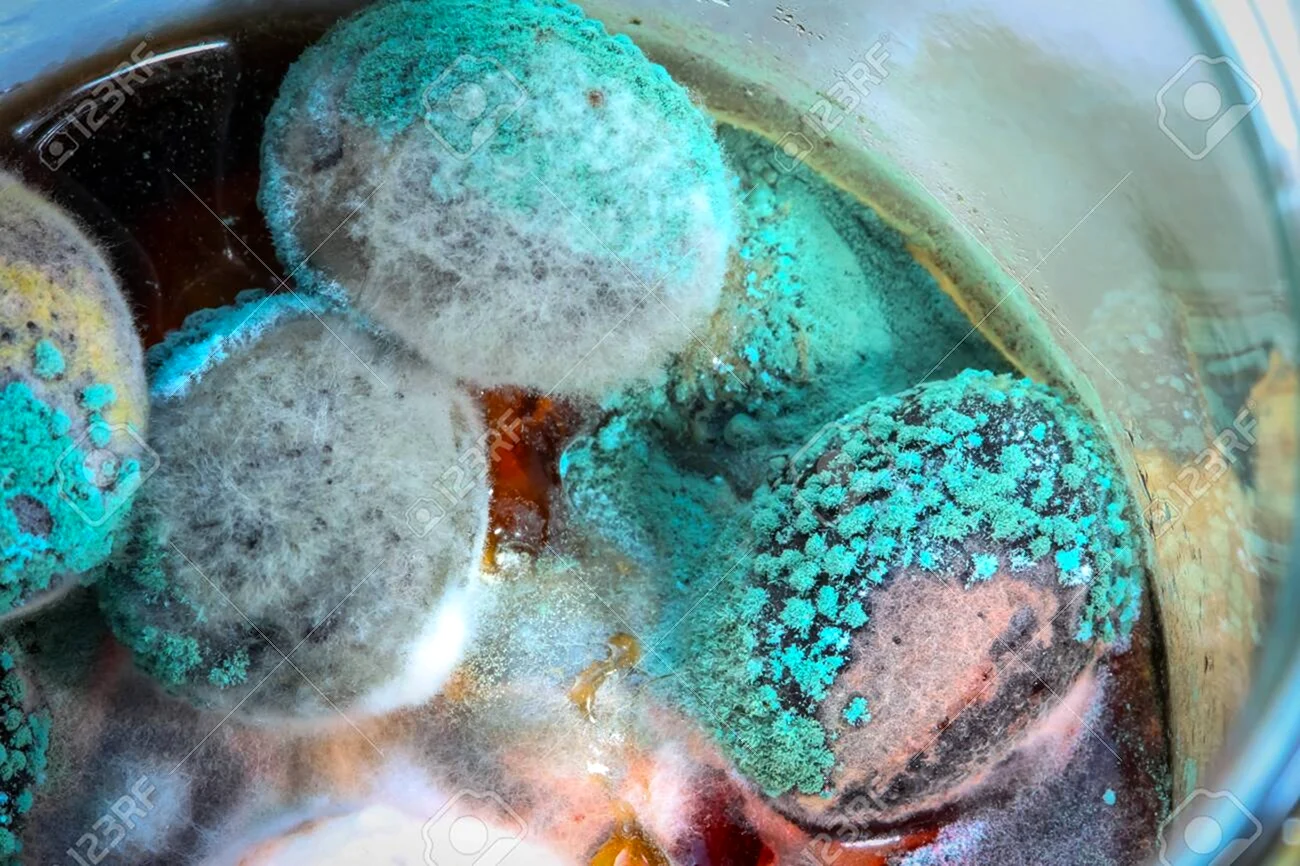
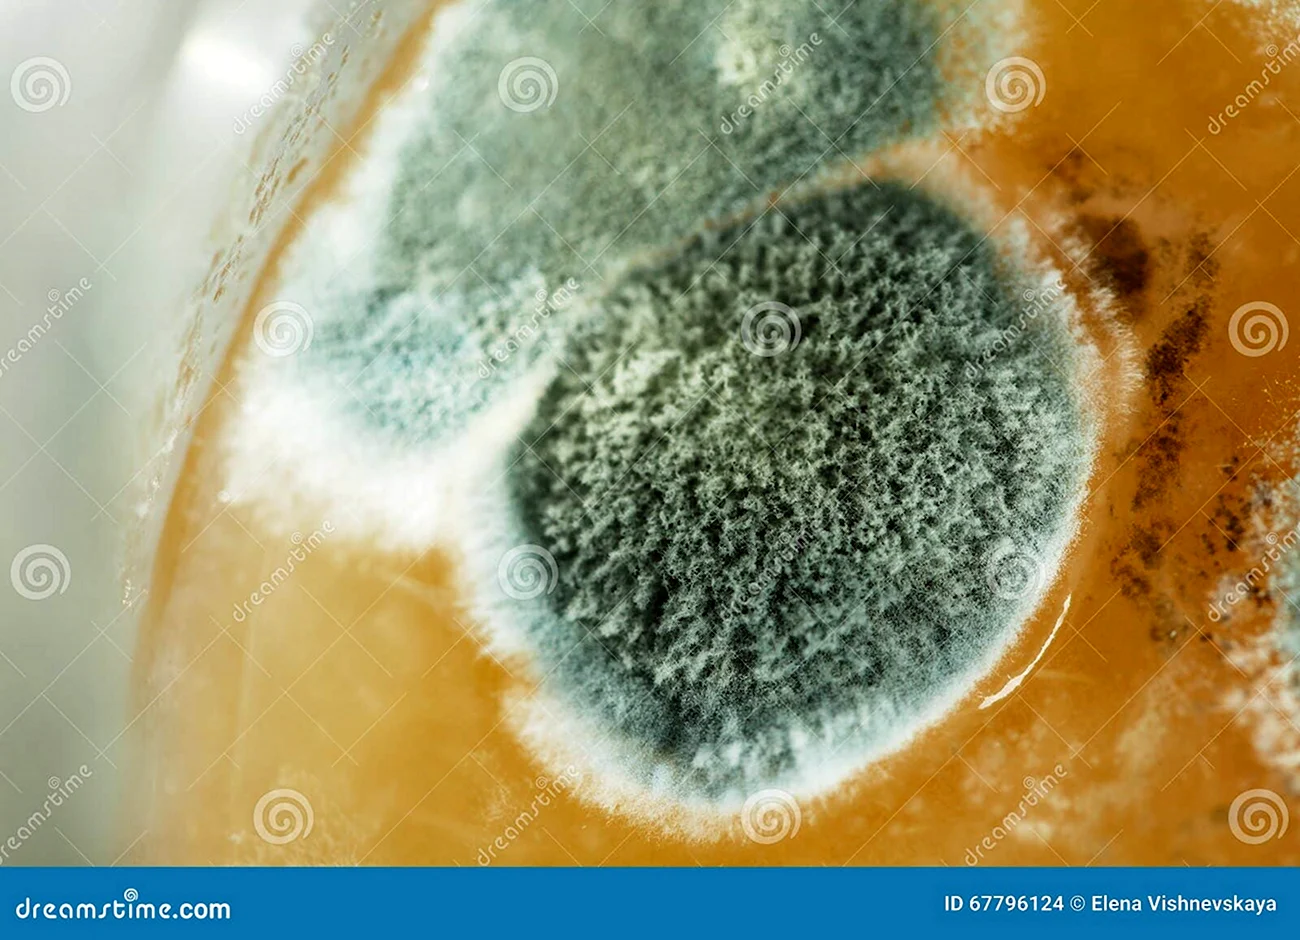
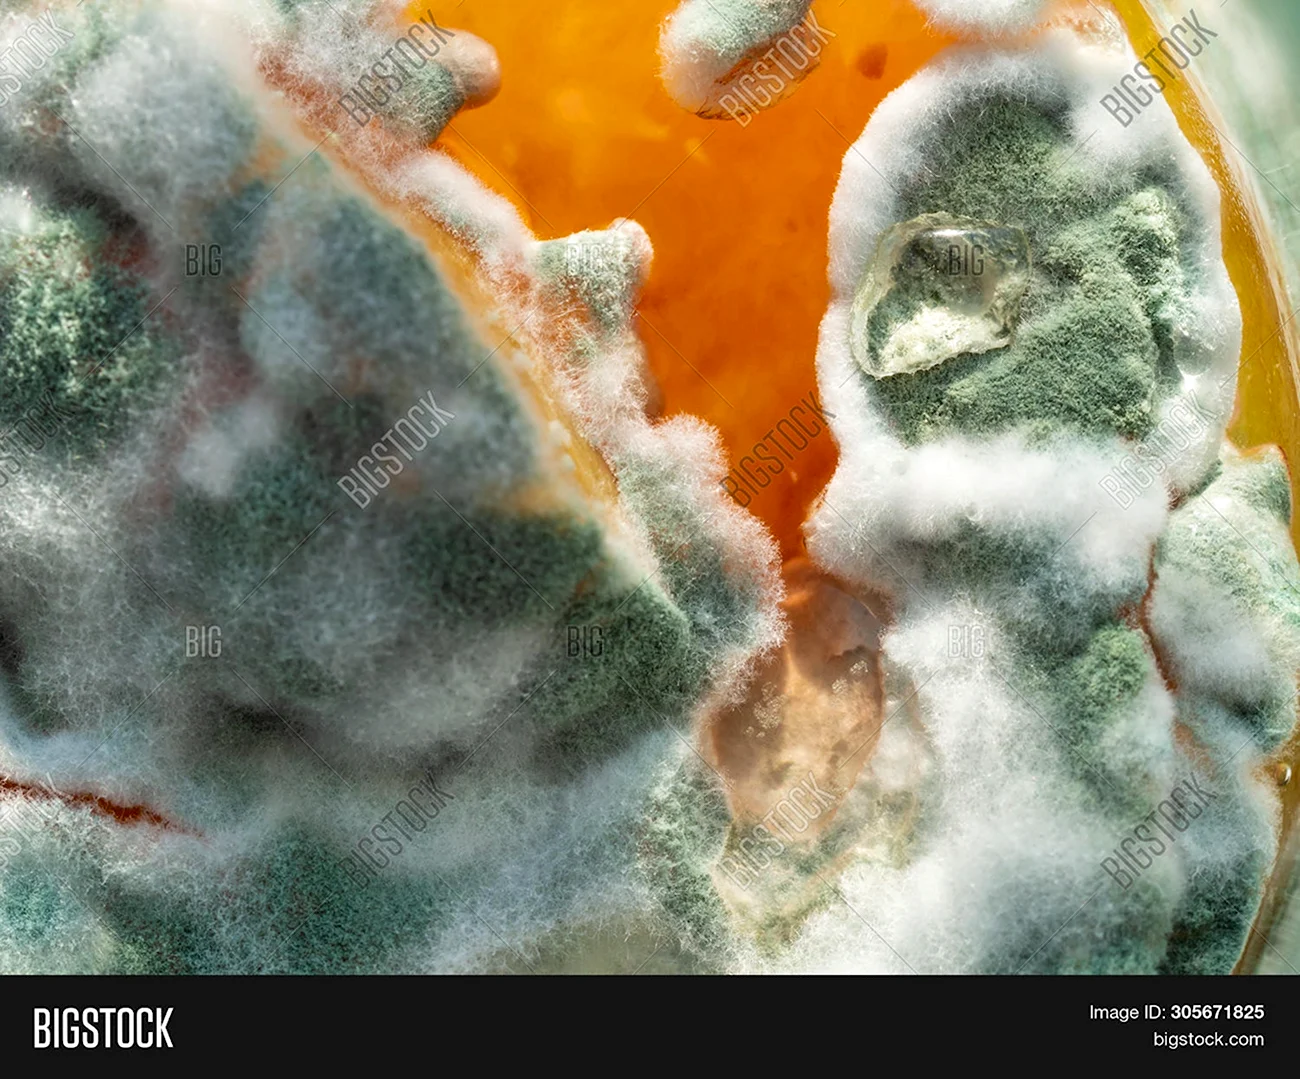
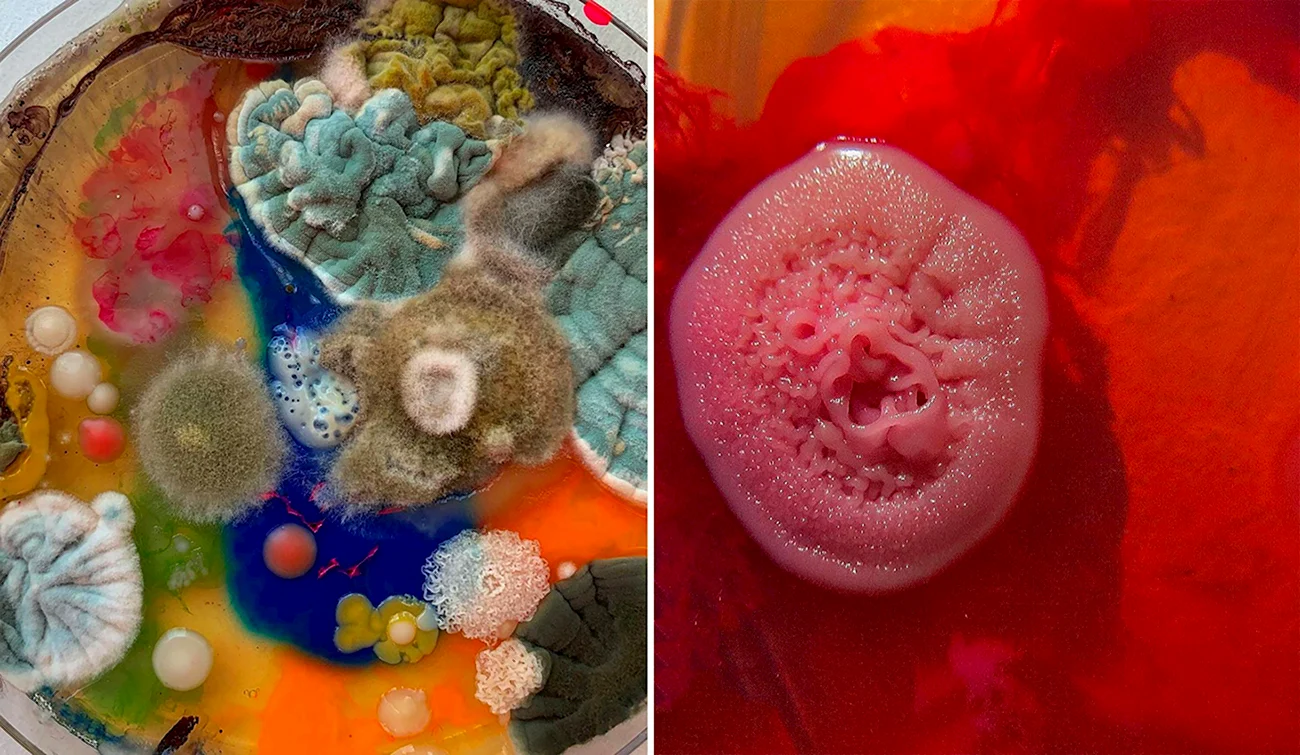
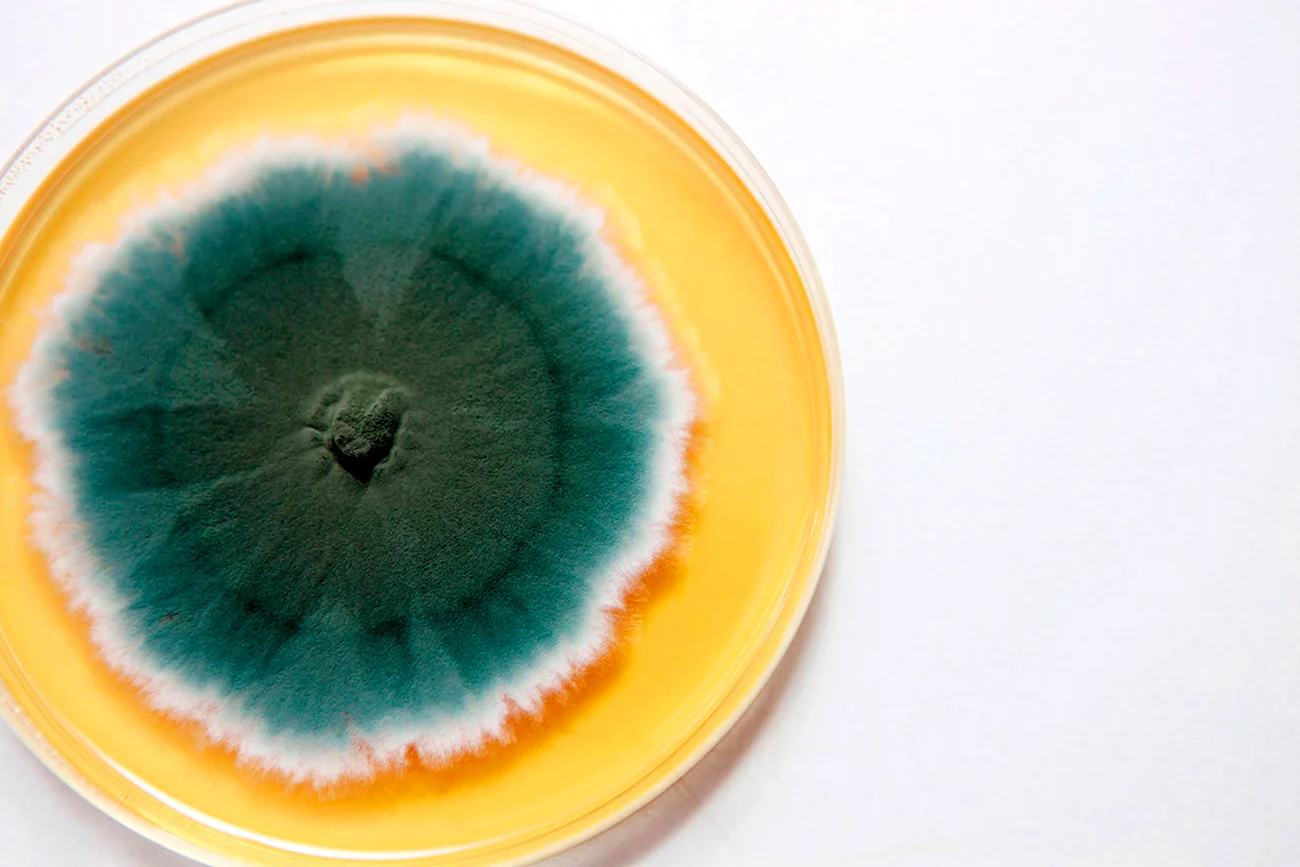

В данной статье представлена уникальная галерея из 38 фотографий, демонстрирующих плесень на мармеладе. Удивительные кадры позволят вам рассмотреть каждую деталь этого необычного явления. Просто один взгляд на эти фотографии заставит вас задуматься о природе плесени и вызовет интерес к ней. Не упустите возможность полюбоваться этой коллекцией уникальных картинок, которые вам неоднократно захочется рассмотреть внимательнее. Погрузитесь в мир плесени на мармеладе и узнайте, каким образом она формируется и развивается.

Оцените картинки








Странный день сегодня — хотел сладенького, а нашел плесень на мармеладе. Вот такой сюрприз! Буду теперь внимательнее проверять угощения перед употреблением. А вам такое уже встречалось?
Ой, девочки, вы видели эти фоточки? Мармеладный флорист зацвел в самом неожиданном месте! Я вот думаю, может, это тоже какой-то новый тренд в гурманских угощениях? Ну, или прикол какой-то. В любом случае, настроение поднимает, только вот аппетит как-то сразу пропадает…
Эти ужасные пятна на сладких лакомствах заставляют меня отказаться от удовольствия вкуса.
«Вот это настоящая карамельная жизнь! Когда даже мармелад решает заняться фермерством».
О, ну это прям мармелад с характером! Кажется, кто-то решил добавить немного экстравагантности в мой завтрак!